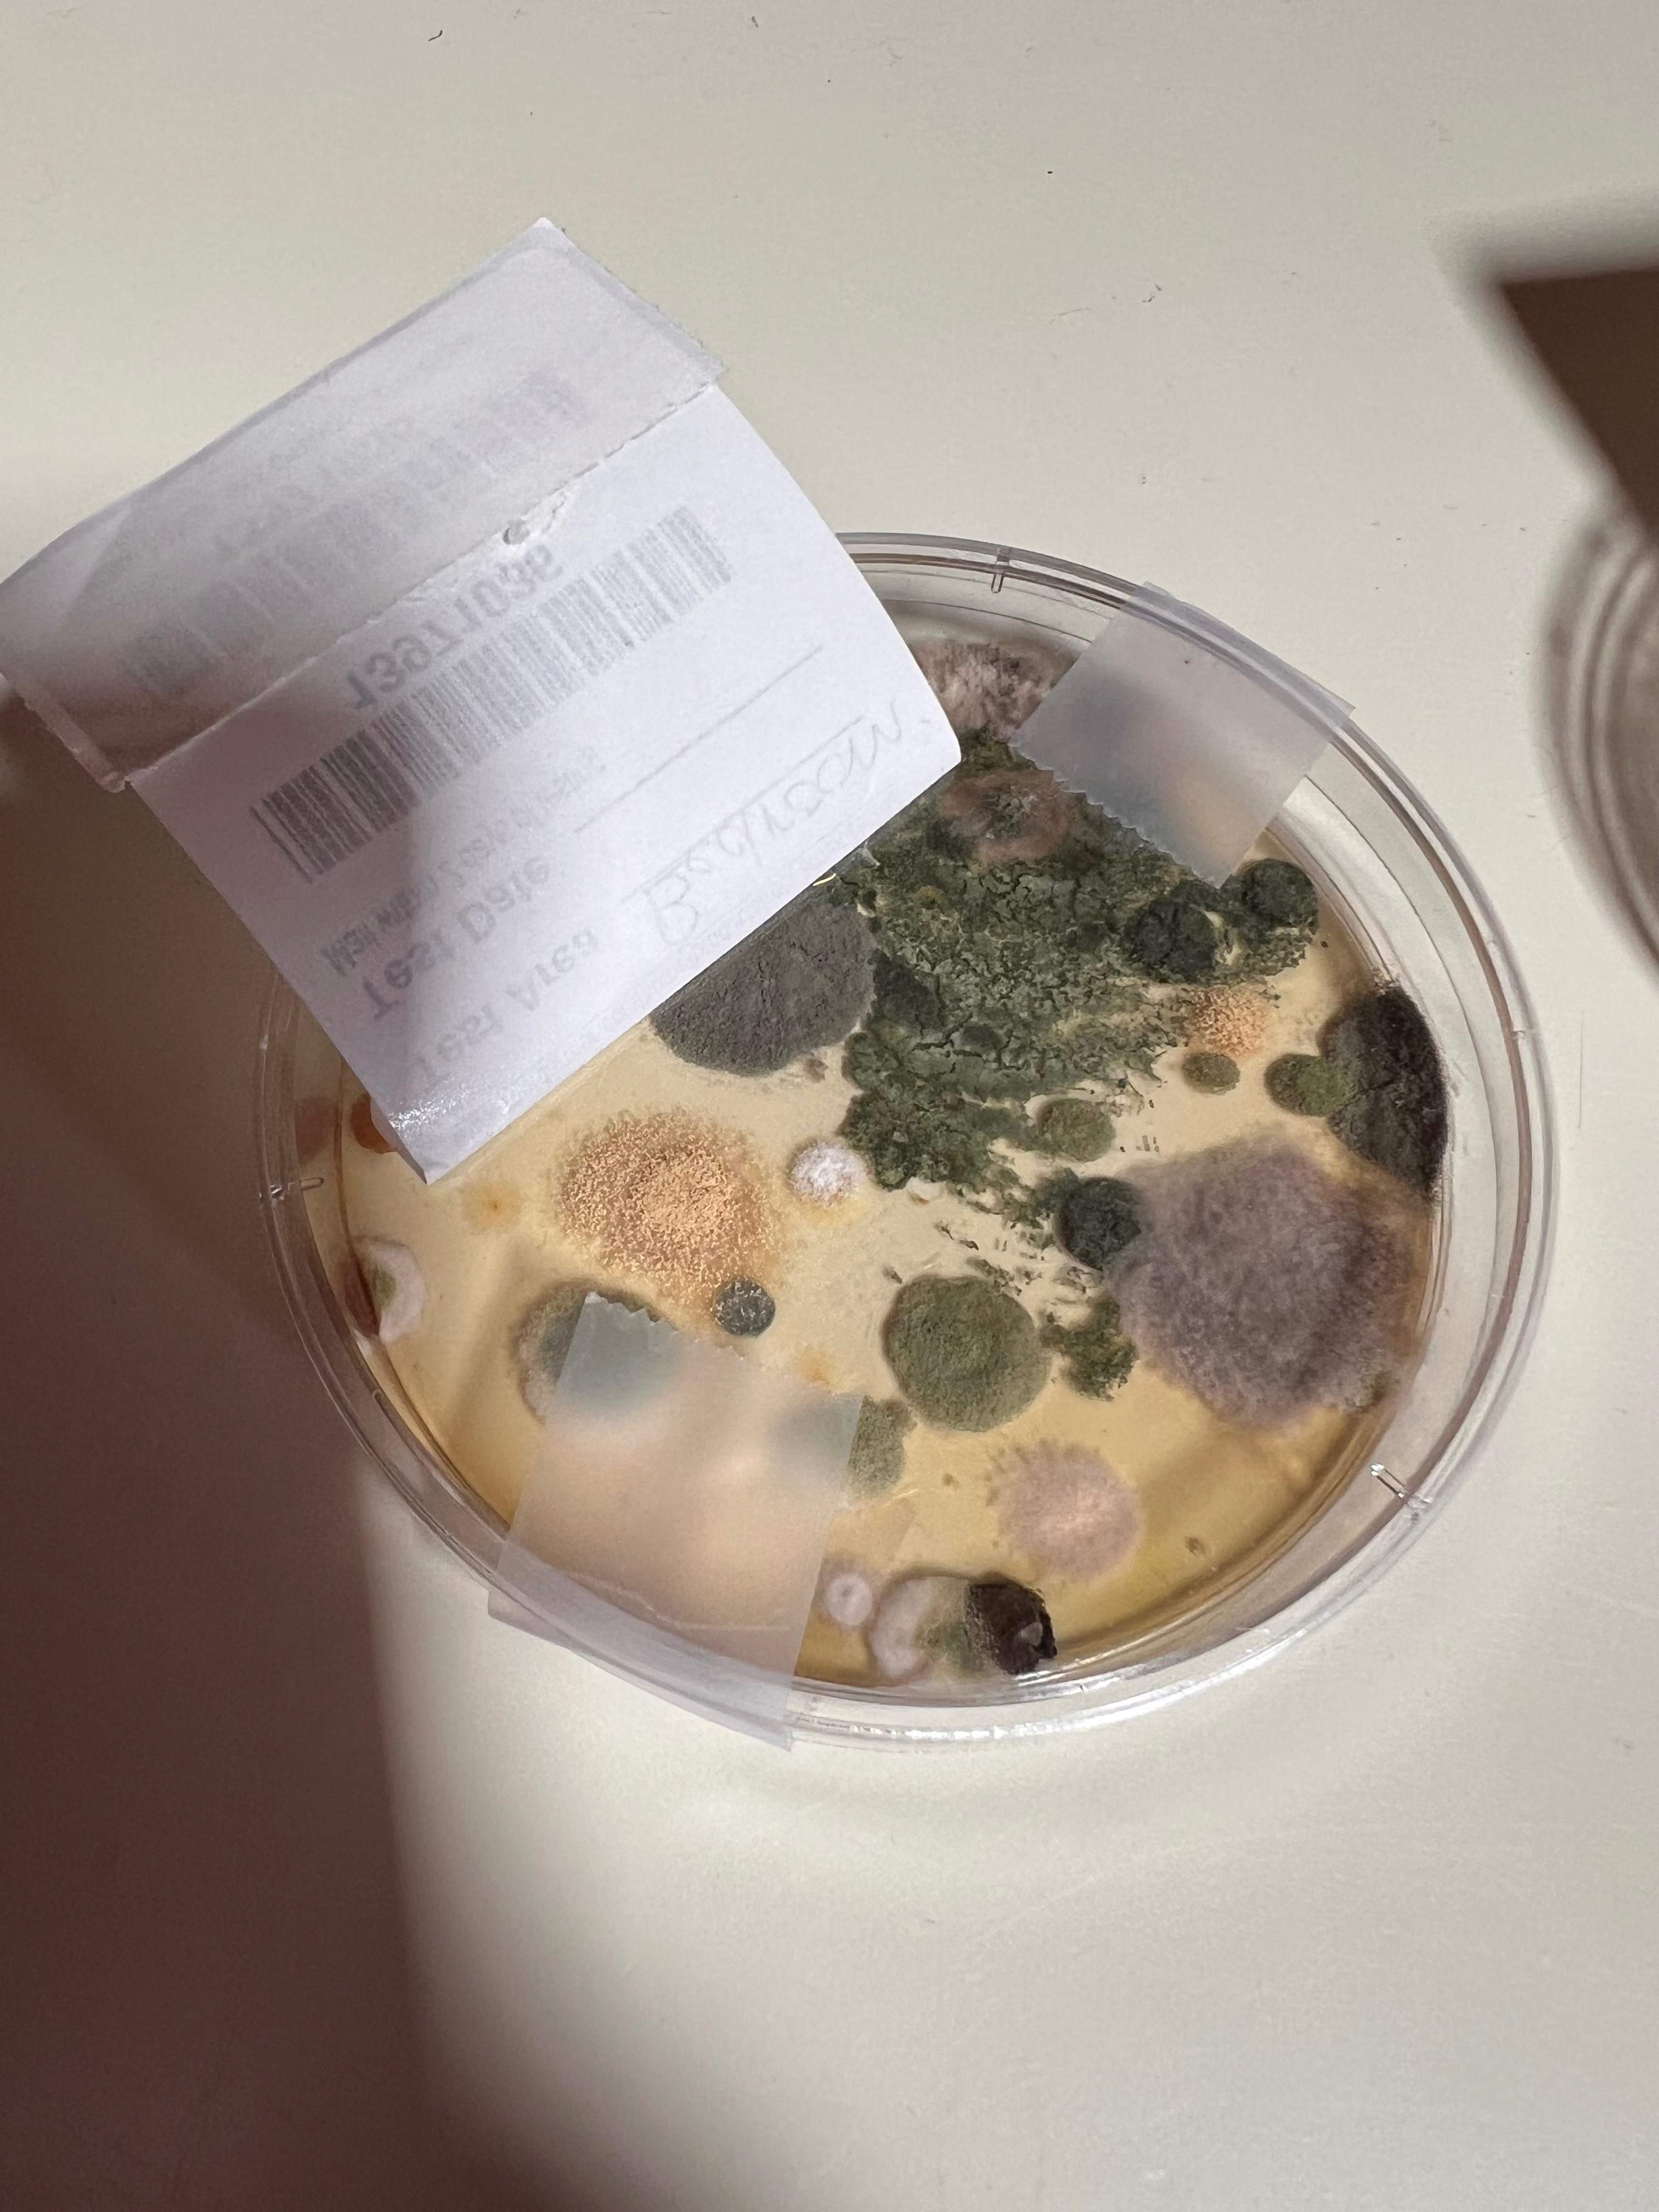
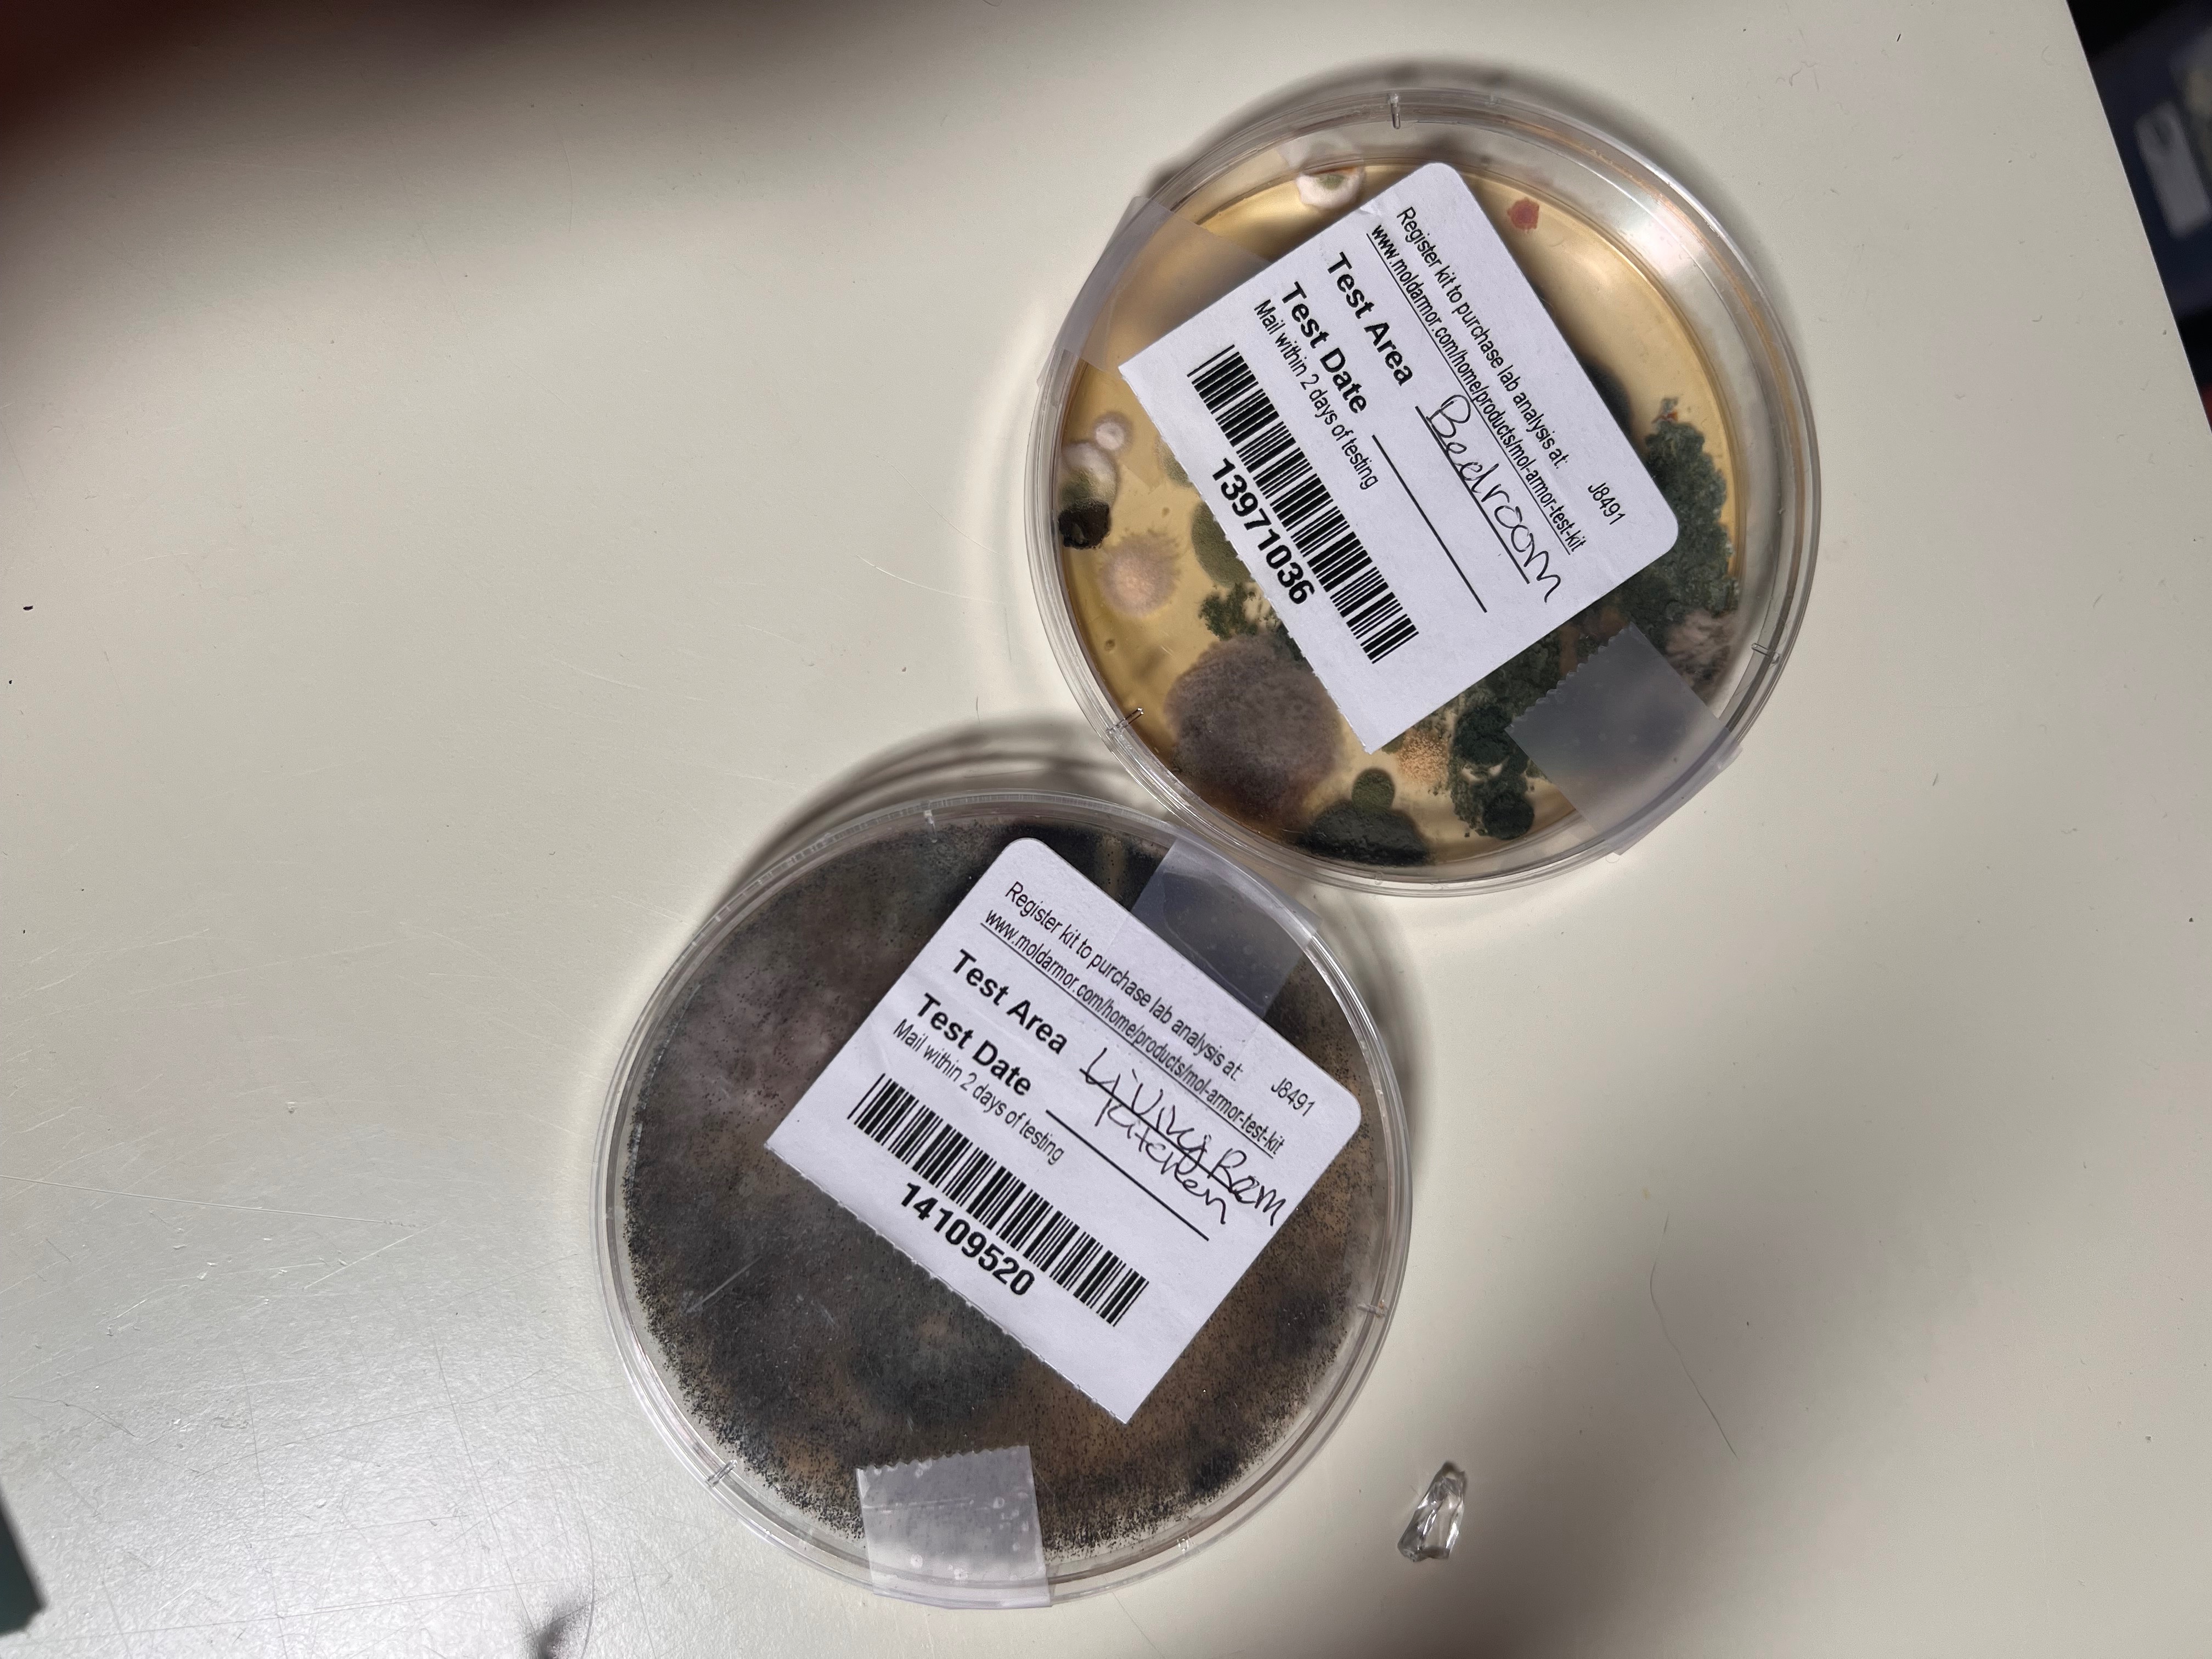

- J
- B
We’re living in dangerous conditions that are harming our children — and we need urgent help to fix it or find a safe place to live.
⸻
Our story
We are the Pendergast family: Cherish & Frank, our three children, two dogs, six cats, two goats, two pigs, and many chickens. We dreamed of building a family farm named Alvarina Acres in memory of Frank’s late mother, Alvarina Dutra Pendergast — a survivor herself.
But today, we’re in crisis. Our home has severe black mold contamination, roof leaks, rodent infestations, and poor air quality. Our well water is contaminated with E. coli. These conditions are making our kids sick, hurting our mental health, and putting our entire family at risk.
⸻
⚠️ How this happened
We invested everything we had — $37,000 — as a deposit to buy this home off market, trusting the sellers’ promise it was move-in ready. They used our deposit to build their new house, then refused to return it. We were denied a final walkthrough, and when we finally got in after months of delays, we found dangerous mold, a leaking roof, and contamination everywhere.
Now we have nowhere else to go and no funds left to move. We’ve even had to drive hours just to bathe our children safely.
Cherish has been hospitalized from the stress, and our kids are getting sick from the air quality. We are emotionally, physically, and financially exhausted — but we’re still fighting for our family’s safety.
⸻
What we’re raising money for
Your support will help us:
✅ Find temporary or permanent safe housing during repairs — or relocate if needed
✅ Replace the down payment we lost to the sellers, so we can start over safely
✅ Remove mold and install an air purification system
✅ Professionally decontaminate all living areas
⸻
❤️ Why this matters
This isn’t just about fixing a house — it’s about giving our kids clean air, a healthy home to grow up in, and a mother’s peace of mind to keep going.
Frank is a veteran. Cherish built a business for over a decade to support our family without assistance. Asking for help is incredibly hard — but we have no other choice.
Every dollar truly helps and goes directly toward protecting our family’s health and rebuilding our lives. Even just sharing our story makes a difference.
⸻
✨ Follow our journey on Instagram: @alvarina.acres
From the bottom of our hearts, thank you for reading, sharing, and supporting us in this devastating time.
With deep gratitude,
Cherish & Frank Pendergast
and our children, dogs, cats, goats, pigs, and chickens